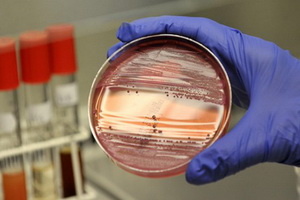

Бруцеллез – заболевание, инфекционного характера, поражающее костно-суставной аппарат, половую и нервную системы организма.
Причиной заболевания всегда являются бактерии Brucella. Они отличаются повышенной устойчивостью, так как могут существовать в воде более месяца, в сыром мясе – до 3 месяцев (в засоленном мясе почти месяц), в молоке – около 40 дней, в брынзе – 2 месяца, в шерсти – до 4 месяцев. По этой причине бруцеллез считается профессиональным заболеванием, больше остальных ему подвержены мясники, ветеринары и фермеры. Между людьми бактерии не передаются, только от животного к человеку.
Симптомы
Первичные проявления заболевания наступают сразу же после того, как в организм проникнет от 10 болезнетворных микроорганизмов и развиваются в первые 7 дней после заражения, но бывает и так, что инкубационный период затягивается вплоть до 1-2 месяцев. Основные пути, по которым инфекция попадает в организм:
- Слизистые оболочки;
- Небольшие царапины и порезы на коже;
- Дыхательные пути;
- Органы пищеварения;
Инфекция проникает в организм человека чаще всего через дыхательные пути, механические повреждения кожи и слизистых оболочек, а также через слизистые оболочки органов пищеварения. Через лимфатические пути инфекция проникает в лимфатические узлы, в которых она размножается и периодически просачивается в кровь.
У каждого человека, перенесшего бруцеллез формируется иммунитет к заболеванию, но лишь на 3-5 лет. После этого человека снова может заболеть.
Не в каждом случае проникшие в организм бактерии приводят к развитию бруцеллеза, так как ответная реакция организма во многом зависит от состояния иммунной системы. В связи с этим, симптоматика у разных людей различна.
У одних появляется общее воспаление организма, у других людей болезнь либо вообще никоим образом себя не проявляет, либо протекает незаметно в хронической форме.
Обычно признаки бруцеллеза у человека имеют большую схожесть с общим размытым воспалительным процессом в организме и проявляют себя через повышение температуры тела ближе к вечеру (под утро температура возвращается к нормальному значению), повышенное потоотделение, озноб и прочее.
Врачи отмечают, что бруцеллез у человека является инфекционным заболеванием, вызванным бактериями рода Brucella. Основными источниками инфекции являются животные, такие как крупный рогатый скот, овцы и козы. Инфицирование происходит при контакте с больными животными или через употребление непастеризованного молока и молочных продуктов. Симптомы заболевания могут варьироваться, но чаще всего проявляются в виде лихорадки, потливости, усталости и болей в мышцах и суставах. Врачи подчеркивают важность профилактики, которая включает в себя соблюдение правил гигиены, вакцинацию животных и отказ от употребления непроверенных молочных продуктов. Ранняя диагностика и лечение играют ключевую роль в предотвращении осложнений, поэтому при появлении подозрительных симптомов следует немедленно обратиться к специалисту.

Острый
Важнейший симптом острого бруцеллеза у человека это лихорадка (от 39 и до 40oС). При этом больной с температурой тела 39o C чувствует себя нормально, может читать и смотреть телевизор. Такая форма заболевания не представляет опасности для жизни и всегда, даже без соответствующего медикаментозного лечения, она заканчивается выздоровлением человека.
Хронический
Хронический бруцеллез всегда сопровождается синдромом общей интоксикации (болит голова, появляется общая слабость).
К общим симптомам относят невысокое, но стойкое повышение температуры тела, ухудшение сна, снижение активности, вспыльчивости и ухудшение аппетита. Кроме того, у больных отмечается поражение половой и нервной систем, а также поражение суставов.
Чаще всего хроническая форма проявляется через суставную и мышечную боль. Причем поражаются главным образом крупные суставы (тазобедренные, локтевые, коленные). Проявляется это через припухлость и ограничение подвижности суставов, но кожа на них не меняет своего цвета.
Бруцеллез — это инфекционное заболевание, вызываемое бактериями рода Brucella, которое передается человеку в основном от животных. Люди, работающие с сельскохозяйственными животными, особенно подвержены риску. Основные симптомы включают лихорадку, потливость, усталость, головные боли и боли в мышцах. Важно отметить, что болезнь может проявляться в хронической форме, что затрудняет диагностику и лечение.
Профилактика бруцеллеза заключается в соблюдении гигиенических норм при работе с животными, а также в употреблении пастеризованного молока и мясных продуктов. Вакцинация животных также играет ключевую роль в снижении заболеваемости. Люди должны быть осведомлены о рисках и проявлять осторожность, особенно в сельских районах, где бруцеллез распространен. Обращение к врачу при первых симптомах поможет избежать серьезных осложнений и обеспечить своевременное лечение.

Лечение
Методы и принципы лечения бруцеллеза у человека напрямую зависят от типа заболевания. Если для лечения острой формы требуется лишь антибиотикотерапия, то с хронической формой болезни приходится бороться вакцинотерапией, усиленной антибиотикотерапией (предназначена для усиления воздействия основного лечения).
Острая форма бруцеллеза требует усиленного лечения, для этого обычно применяются большие дозы антибиотиков. Причем их дозировка определяется только врачом, так как слабое или не доведенное до конца лечение неизменно приводит к тому, что заболевание перетекает в хроническую форму. Поэтому лечение осуществляется на протяжении определенного врачом промежутка времени и без каких-либо перерывов, до полного выздоровления.

Для лечения этой формы болезни применяют кроветворные стимуляторы (неспецифические) и витамины в комплексе. Зимой лечебные мероприятия обязательно усиливают курсом общего ультрафиолетового облучения. Чтобы достичь максимального эффекта нередко используют антигистаминные средства. Для борьбы с воспалительными изменениями обычно применяют кортикостероидные препараты.
Для укрепления иммунной системы и десенсибилизации прибегают к помощи вакцинотерапии. С этой целью чаще всего применяют бруцеллин, если заболевание осложняется характерной аллергической перестройкой. При этом наиболее распространенной формой вакцины является так называемая «мертвая вакцина», живую используют крайне редко, только в профилактических целях.
Особую роль играет дозировка вакцины и способ ее введения (ошибки приводят к обострению заболевания или в лучшем случае к отсутствию эффекта от лечения). На сегодняшний день вакцину вводят внутрь кожи, внутримышечно, подкожно и внутривенно.
Стоит отметить, что на сегодняшний день самими распространенными способами введения вакцины являются подкожный и внутрикожный способы. Под кожу лекарство вкалывают при ярко выраженном процессе и его ухудшении. Однако сначала больному вводят от 10 и до 50 миллионов клеток микробов определяя таким образом реакцию организма на такой способ лечения. При отсутствии общей и местной реакции лечение вакцинотерапией в полной мере начинается уже со следующего дня.
В отличие от подкожного введения вакцины внутрикожный способ лечения считается более щадящим, поэтому его применяют на стадии компенсации и для предотвращения перехода болезни в латентную форму. Основываясь на выраженности реакции на внутрикожное введение, врачи подбирают наиболее подходящую концентрацию лекарства (реакция представляет собой покраснение на коже диаметром 5-10 миллиметров).
Последствия
Как уже упоминало выше, неправильное или незавершенное лечение нередко ставится причиной хронической формы болезни. Наиболее опасным последствием является инвалидность, обусловленная сильным поражением опорно-двигательного аппарата. Однако прогноз для жизни при любой форме бруцеллеза положителен. У некоторых беременных женщин из-за осложнений дети рождаются мертворожденными или появляются на свет преждевременно (нередки и выкидыши). Важно помнить, что у 20-30% больных, у которых полностью исчезли все симптомы бруцеллеза наступает обострение болезни.
Профилактика
Это довольно тяжелая задача, так как бактерии легко проникают в организм человека от больных животных. Поэтому, чтобы предотвратить бруцеллез у человека необходимо своевременно изолировать всех больных животных при малейшем подозрении на инфекцию.
Однако самостоятельно уничтожать больной скот нельзя, этим занимаются специально обученные люди на специально оборудованных всем необходимым площадках.
Животным неоднократно вводят вакцину предотвращающую распространение бактерий и умерщвляют их с соблюдением всех санитарных норм.
Все помещения с больным скотом регулярно дезинфицируются. Для обеззараживания шерсти используют бромистый метил, а кожу животного с этой же целью засаливают на несколько месяцев.
Работники мясокомбинатов и кожевенных фабрик в обязательном порядке должны применять различного рода защитные средства (комбинезоны, респираторы, резиновые перчатки и сапоги, халаты и прочее). Также всем сотрудниках подобных предприятий ежегодно делают прививки для предотвращения развития заболевания.
Вопрос-ответ
Какие симптомы характерны для бруцеллеза у человека?
Острый бруцеллез. Начинается заболевание остро с резкого повышения температуры тела до фебрильных цифр. Сопровождается оно потрясающим ознобом и проливными потом, артралгиями, миалгиями, ощущением выраженной слабости и разбитости, бессонницей, нарушением аппетита, эмоциональной лабильностью.
Что будет, если человек болеет бруцеллезом?
Бруцеллёз может стать причиной развития патологии практически всех органов человека. От того, какой орган будет поражен, зависит клиническая картина заболевания: сердце (миокардит, тромбофлебит, абсцесс корня аорты), легкие (пневмония, бронхит).
Какой анализ крови показывает бруцеллез?
Определение IgG позволяет подтвердить диагноз бруцеллёза. Также его назначают с целью дифференциальной диагностики бруцеллёза и полиартритов другой этиологии. Исследование более информативно вместе с определением IgM.
Какой орган поражает бруцеллез?
Заболевание носит системный характер и поражает опорно-двигательный аппарат человека, нервную систему и репродуктивные органы, провоцируя развитие сопутствующих недомоганий.
Советы
СОВЕТ №1
Обязательно соблюдайте правила личной гигиены при работе с животными и их продуктами. Используйте перчатки и защитную одежду, особенно если вы находитесь в контакте с больными животными или их биологическими жидкостями.
СОВЕТ №2
Избегайте употребления непастеризованного молока и молочных продуктов. Убедитесь, что все молочные изделия, которые вы покупаете, прошли термическую обработку, чтобы снизить риск заражения бруцеллезом.
СОВЕТ №3
Регулярно проходите медицинские осмотры, особенно если вы работаете в сельском хозяйстве или на фермах. Это поможет выявить возможные симптомы заболевания на ранних стадиях и начать лечение.
СОВЕТ №4
Обучайте своих близких и коллег о симптомах и профилактике бруцеллеза. Чем больше людей будет осведомлено о рисках и способах защиты, тем ниже вероятность распространения инфекции.